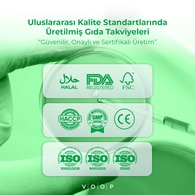
VOOP VOOP Voop Probiyotik Mikroorganizma İçeren 10'lu Saşe Takviye Edici Gıda  1 of 8

Watsons Mağazadan Hızlı Teslim
Siparişin 1 saat içerisinde seçtiğin mağazamızda hazır olacak! 7 gün içinde dilediğin zaman gelip alabilirsin. Sana en yakın mağazamızı seçmek için tıkla!

Watsons Adresine Teslim
İster evine, ister ofisine, ister arkadaşına! Dilediğin adresi gir, siparişini o adrese teslim edelim.

Watsons Mağazadan Teslim
Siparişini dilediğin Watsons mağazasına teslim edelim, bilgilendirme geldiğinde siparişini gel al!

Watsons Club
/image-20251001-130333-1-.png)
Kredi Kartı / Banka Kartı

Hediye Kartı
Ürün Açıklaması
Ürün Açıklaması
Voop Probiyotik Mikroorganizma İçeren 10'lu Saşe Takviye Edici Gıda Nedir?
Voop Probiyotik Mikroorganizma İçeren 10’lu Saşe Takviye Edici Gıda sindirim sistemini düzenlemeye ve bağışıklık sistemini desteklemeye yardımcı olan dost bakterileri içeren ileri teknoloji bir takviyedir. İçeriğinde bulunan milyarlarca aktif probiyotik mikroorganizma sayesinde bağırsak florasının doğal dengesini korumayı hedefler. On adet tek kullanımlık saşe formunda sunulan bu ürün, mide asidine karşı dirençli özel yapısı sayesinde aktif bileşenlerin bağırsaklara canlı bir şekilde ulaşmasını sağlayacak şekilde formüle edilmiştir. Modern yaşamın getirdiği düzensiz beslenme, stres veya antibiyotik kullanımı gibi florayı olumsuz etkileyebilecek faktörlere karşı vücudun iç dengesini yeniden kazanmasına destek olan profesyonel bir bakım sunar.
Voop Probiyotik Mikroorganizma İçeren 10'lu Saşe Takviye Edici Gıda Nasıl Kullanılır?
Voop Probiyotik Mikroorganizma İçeren 10'lu Saşe Takviye Edici Gıda günlük rutine entegre edilmesi oldukça kolay ve pratik bir kullanım protokolüne sahiptir. Yetişkinler için önerilen kullanım şekli günde bir adet saşenin yaklaşık iki yüz mililitre su, yoğurt veya oda sıcaklığındaki herhangi bir içecek ile karıştırılarak tüketilmesidir. Dikkat edilmesi gereken en önemli nokta, probiyotiklerin canlılığını koruyabilmesi için ürünün çok sıcak içeceklerle temas ettirilmemesidir. Genellikle sabah kahvaltısından önce veya akşam yemeği sırasında tüketilmesi önerilmekle birlikte, vücudun biyolojik ritmine uygun olarak her gün aynı saatte kullanılması biyoyararlanımı artırır. On günlük kür şeklinde tasarlanan bu onlu paket, özellikle mevsim geçişlerinde veya sindirim sisteminin ek desteğe ihtiyaç duyduğu dönemlerde güvenle tercih edilebilir.
Voop Probiyotik Mikroorganizma İçeren 10'lu Saşe Takviye Edici Gıda Ne İşe Yarar?
Bu ürünün temel amacı sindirim sistemindeki mikroorganizma popülasyonunu dengeleyerek şişkinlik ve sindirim düzensizlikleri gibi problemlerin azalmasına yardımcı olmaktır. İçeriğindeki dost bakteriler bağırsak bariyerini destekleyerek zararlı mikroorganizmaların çoğalmasını engellemeye ve besinlerin emilimini daha verimli hale getirmeye destek olur. Bağışıklık sisteminin büyük bir kısmının bağırsaklarda yer alması nedeniyle, bu takviye aynı zamanda vücut direncinin artmasına ve genel zindelik halinin korunmasına katkıda bulunur. Sadece sindirim konforu sağlamakla kalmaz, aynı zamanda bağırsak sağlığı ile doğrudan ilişkili olan cilt görünümü ve enerji seviyeleri üzerinde de dolaylı olarak olumlu bir etki yaratmayı hedefler.
Voop Probiyotik Mikroorganizma İçeren 10'lu Saşe Takviye Edici Gıda Kimler İçin Uygundur?
Voop Probiyotik Mikroorganizma İçeren 10'lu Saşe Takviye Edici Gıda sindirim sistemi hassasiyeti yaşayan, düzensiz beslenme alışkanlıklarına sahip olan veya bağışıklığını güçlendirmek isteyen tüm yetişkinler için uygundur. Özellikle antibiyotik kullanımı sonrasında bozulan bağırsak florasını onarmak isteyenler veya seyahat dönemlerinde değişen beslenme düzenine bağlı sindirim sorunları yaşayan bireyler için ideal bir destektir. Şehir hayatının getirdiği yoğun stres ve hava kirliliği gibi oksidatif stres yaratan durumlarda vücudun iç dengesini korumak isteyen kişiler de bu ürünü rutinlerine dahil edebilirler. Katkı maddesi ve yapay tatlandırıcı içermeyen temiz içeriği sayesinde, sağlıklı yaşamı odağına alan ve fonksiyonel beslenmeye önem veren kullanıcılar için güvenli bir alternatiftir.
Voop Probiyotik Mikroorganizma İçeren 10'lu Saşe Takviye Edici Gıda Saklama Koşulları Nelerdir?
Voop Probiyotik Mikroorganizma İçeren 10'lu Saşe Takviye Edici Gıda içeriğindeki mikroorganizmaların canlı ve aktif kalabilmesi için uygun koşullarda saklanması büyük önem taşır. Ürünün doğrudan güneş ışığı almayan, serin ve nemsiz bir ortamda muhafaza edilmesi gerekmektedir. Saşe formu, her bir dozu dış etkenlere, neme ve havaya karşı koruyarak ürünün son kullanma tarihine kadar stabilitesini korumasını sağlar. Buzdolabında saklama zorunluluğu bulunmamakla birlikte, oda sıcaklığının yirmi beş derecenin üzerine çıktığı durumlarda daha serin bir alanda tutulması tavsiye edilir. Paket açıldıktan sonra saşe içeriği bekletilmeden tüketilmeli ve ürünün ambalaj bütünlüğü bozulmuş paketler kullanılmamalıdır.
Voop Probiyotik Mikroorganizma İçeren 10'lu Saşe Takviye Edici Gıda Etken Maddeleri Nelerdir?
Voop Probiyotik Mikroorganizma İçeren 10'lu Saşe Takviye Edici Gıda içerisinde sinerjik bir etki yaratan çeşitli probiyotik suşları ve bu bakterilerin besini olan prebiyotik bileşenler barındırır. Formülün merkezinde Lactobacillus ve Bifidobacterium gibi insan sağlığı için kritik öneme sahip, klinik olarak araştırılmış mikroorganizma suşları yer alır. Bu probiyotiklere eşlik eden İnülin veya FOS gibi prebiyotik lifler, dost bakterilerin bağırsakta daha hızlı çoğalmasını ve tutunmasını destekler. Ürün ayrıca probiyotiklerin metabolik aktivitelerini destekleyen esansiyel vitamin ve minerallerle zenginleştirilmiştir. Her bir saşe, hedeflenen faydayı sağlayacak miktarda canlı birim içeren, şeker ve glüten içermeyen optimize edilmiş bir içerik profiline sahiptir.
Kullanımlar
Kullanımlar
İçerik Maddeleri
İçerik Maddeleri
İptal İade Koşulları
İptal İade Koşulları
İptal Koşulları:
Sipariş adımlarını tamamlayarak ödemenizi gerçekleştirdikten sonra siparişinizin iptali için talep oluşturabilirsiniz. Talebinizi oluşturmak için sipariş numaranızla birlikte 0850 755 9987 numaralı İletişim Merkezimizi aramanız gerekmektedir. İptal talepleri İletişim Formumuz üzerinden yapılamamaktadır. İptal talepleri yalnızca siparişinizde bulunan ürünlerin depomuzda toplanma işlemi başlamamışsa değerlendirmeye alınabilmektedir. Sipariş verdiğiniz ürünlerin toplanma süreci başladıktan sonra iptal işlemi yapılamamaktadır. Böyle durumlarda iade talebi oluşturabilirsiniz.
İade Koşulları:
Sitemiz üzerinden vermiş olduğunuz siparişlerle ilgili iade taleplerinizi sipariş numaranız ile birlikte 0850 755 9987 numaralı İletişim Merkezi hattımızı arayarak oluşturabilirsiniz. İade talebinizin olumlu sonuçlanması durumunda İletişim Merkezimizin sağlayacağı Kargo İade kodunu kullanarak DHL Kargo ile satın almış olduğunuz ürünleri iade edebilirsiniz. Ambalajı açılmış, kullanılmış ya da tekrar satışa engel durumu olan ürünler için iade işlemi yapılamamaktadır.Şampuan, duş jeli, cilt ve saç bakım ürünleri gibi iadesi sağlık ve hijyen açısından uygun olmayan ürünler için iade yapılamamaktadır. Koruma ambalajı bulunan makyaj, cilt bakım ürünlerinde de koruma bandı açıldığı takdirde iade işlemi yapılamamaktadır. İade etmek istediğiniz ürünlerin bu koşulları karşılamaması durumunda iade onayı iptal edilerek Yurtiçi Kargo ile ürünleriniz Alıcı Ödemeli olarak tarafınıza gönderilecektir. İptal ve iade süreçleri hakkında detaylı bilgi için İptal & İade sayfamızı ziyaret edebilirsiniz.
Ürün Detay Bilgisi
Ürün Detay Bilgisi
Ürüne henüz yorum yazılmamış